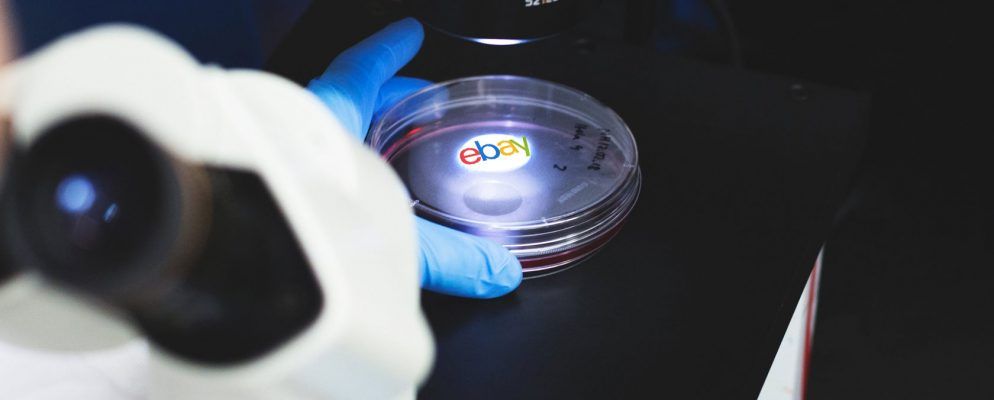
10个适用于极客的eBay高级搜索提示

使用该网站一段时间后,您可能想要在线搜索方式变得更有效率。不用担心您来对地方了。这里有10个eBay高级搜索技巧。
如何访问eBay高级搜索

eBay具有强大的高级搜索工具。它为高级用户提供了一种更加专注于他们所寻找内容的方法。
在本文中,我们将向您介绍高级搜索工具的一些最有用的部分。 ,然后继续向您展示一些其他的高级搜索提示,这些提示并不立即显而易见。
但是,首先,您需要了解如何访问eBay上的高级搜索工具。这简单;只需转到eBay的主页,登录到您的帐户,然后单击右上角的高级搜索链接即可。
在“高级搜索"页面的左侧,您应该看到导航菜单。在主窗口中有各种搜索工具。
1。如何在eBay上使用卖家搜索

在eBay卖家搜索中,您可以从指定的人或特定人群中查找商品。
例如,您可以使用该工具添加或排除特定人员,仅在收藏夹列表中搜索卖家中的商品,或仅在结果中包含拥有eBay商店的人员(而不是一次性的单个卖家)。
要使用卖家搜索功能,打开高级搜索窗口,然后点击左侧面板中的商品>卖方。
确保选中旁边的复选框>仅显示中的项目,然后根据需要设置搜索字词和参数。
2。如何使用eBay商店搜索

尽管您可以使用eBay卖家搜索来查找eBay商店,但还有一种更简化的方法。作为其高级搜索工具的一部分,eBay包括商店搜索。
在左侧面板中需要查找两个链接:商店>商店中的商品和< strong>商店>查找商店。您可以使用任何一种工具来查找所需的产品。
3。如何在eBay上搜索商品

当然,eBay的基本搜索本质上是一项商品搜索-只需键入查询并按 Enter 。但是,“高级搜索"页面也主要用于执行eBay物品搜索。
让我们仔细看看其中四个最有用的过滤器。
购买格式: eBay为人们销售产品提供了两种不同的方式:拍卖和“立即购买"。如果您只想查看两个类别之一的结果,则可以在其中应用过滤器。
价格:没有人愿意花大钱买高价的tat。如果预算有限,则可以输入首选的价格范围。
条件: eBay的性质意味着您会发现很多其他东西全新的。您可以按“新建",“二手"和“未指定"过滤结果。
列表::列表过滤器可让您查看拍卖即将结束的物品,具有特定编号的物品到目前为止的出价以及列出要出售的物品。
4。如何在eBay上搜索商品编号

奇怪的是,高级搜索主页面中不包含eBay商品编号搜索。相反,您需要单击左侧面板中的按项目编号。
页面加载完成后,在下面的文本框中键入该项目的参考代码>输入商品编号。点击搜索以查看结果。
5。如何在eBay上搜索用户

通过eBay用户搜索,即使用户不是卖家,也可以找到用户。您只需要知道此人的电子邮件地址或用户ID。
奇怪的是,单击主页上的“高级搜索"链接时,成员搜索功能不再列出。
单击该链接时,左侧面板中应出现两个新的隐藏链接:查找成员和查找联系信息。
如果要输入某人的联系信息,请使用查找成员。如果您想在最近的交易后从eBay请求某人的联系信息,请单击“查找联系信息"。
6。如何在eBay上搜索已售商品

在拍卖中出售某商品时,其列表很快从常规搜索结果中消失; eBay不想向您宣传无法购买的产品。
但是,仍然可以搜索已售出的商品。如果您想了解是否有人买了您之前看到的东西,这很有用。如果没有,您可以睁开眼睛,让它在将来的某个时刻再次弹出。
要在eBay上搜索已售出的商品,请转到高级搜索>物品>查找项目>搜索包括,然后选中已售商品旁边的复选框。
The sold items search is also an excellent tool for sellers ; it can give you a ballpark figure for the amount you should list your item for.
7。如何在eBay上进行全球搜索

您正在寻找的梦item以求的东西可能在您所在的地区不可用,但这并不意味着世界上某个地方的人都没有在出售它。
eBay使您可以通过其高级搜索工具搜索其整个全球列表。转到项目>查找项目>位置开始。
您将看到三个选项。您可以设置半径(对于可能需要亲自收集的大型物品有用),按区域设置首选位置,以及按国家/地区设置首选位置。
要执行全局搜索,请选择从首选位置旁边的下拉菜单中的全球。
其他有用的eBay高级搜索提示
这里有三个

也许您经常在eBay上搜索相同的内容,例如从您最喜欢的运动队签名的纪念品。
在这种情况下,最好进行保存的搜索。不仅可以节省您在网站上的时间,而且每次列出符合您的搜索条件的新项目时,它还会向您发送警报。
要保存搜索,请单击在结果列表顶部的保存此搜索。您可以前往我的eBay>保存的搜索来管理保存的搜索。
世界上似乎有很多人不能拼写“ Yves Saint Laurent" ,“ Christian Louboutin"和其他所有顶级时尚品牌。
您可以根据自己的知识来使用它。尝试使用故意拼写错误的单词运行eBay搜索;您会找到所有其他人都没有出价的产品。像大多数基于Web的搜索引擎一样,天才吧?
您可以输入布尔命令来精确地优化结果。
有很多布尔命令可用。如果您想学习一些知识,请查阅我们的布尔逻辑指南。
别忘了eBay边栏!
使用常规搜索时,您可以申请通过使用结果列表左侧的侧边栏,可以使用“高级搜索"工具中的某些过滤器。如果您一开始不确定确切要寻找的内容,那么这是优化结果的最佳方法。
如果您想了解更多酷的eBay提示和技巧,请查看我们有关如何使用自动出价赢得拍卖的文章。